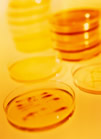
Placas Petri con cultivos bacterianos

|
Placas Petri con cultivos bacterianos |
(Redacción TSB. Web del TSB)
Staphylococcus Aureus es una bacteria que puede colonizar sin causar infección la superficie de la piel y las mucosas de seres humanos y animales. Al mismo tiempo, es un microorganismo capaz de producir un amplio rango de infecciones que oscilan entre las más superficiales y leves en pacientes sanos hasta las más graves en pacientes hospitalizados y con graves enfermedades de base. Las infecciones más graves incluyen las de la sangre (sepsis, bacteriemia), las del pulmón (neumonía), las de las heridas quirúrgicas y las de huesos y articulaciones.
Se estima que entre el 30 y el 50% de los adultos sanos están colonizados, y entre el 10 y el 20% lo están persistentemente. Según el profesor Emilio Bouza, jefe del Servicio de Enfermedades Infecciosas y Microbiología del Hospital Gregorio Marañón y Catedrático del Departamento de Medicina de la Universidad Complutense de Madrid, a lo largo de la vida, todas las personas van a tener una de estas infecciones, aunque las más graves son menos frecuentes. Hoy en día esta bacteria es una de las que más infecciones hospitalarias causa.
Lo más común es que se transmita con el contacto humano, aunque también puede hacerlo al entrar los tejidos en contacto con material contaminado. Esto ocurre porque esta bacteria habita tanto en las mucosas como en la piel de las personas, de tal manera que, a través del contacto directo o indirecto con el personal sanitario, puede penetrar en la sangre cuando hay una herida.
Se trata de una infección que se disemina con mucha facilidad. Eso no quiere decir que siempre cause problemas, pero cuando hay un factor de riesgo como la infección de un catéter, una cirugía o una prótesis, las personas colonizadas son las que tienen más riesgo de sufrir estas infecciones.
El control del paciente que ingresa en el hospital, fundamental para prevenir la infección
La infección estafilocócica aumenta o disminuye en paralelo a otros factores; en los últimos años ha crecido debido a la mayor implantación de prótesis, a las cirugías cada vez más agresivas, a la implantación de catéteres y, sobre todo, al envejecimiento de la población, es decir, a que haya más personas más debilitadas y más propensas a sufrirlas.
Por ello, según este experto, el futuro del tratamiento de esta bacteria se basa en la prevención, en evitar infecciones, sabiendo y controlando qué pacientes entran a los hospitales ya con la bacteria en su cuerpo, y en tomar medidas eficaces, fundamentalmente la higiene de las manos de los profesionales sanitarios y de las familias y visitantes de los pacientes.
Una vez que se produce, indica el Dr. Bouza, hay que hacer un diagnóstico precoz, mejorando las técnicas en los servicios de microbiología para hacer las detecciones más rápidas y más precisas. Resulta fundamental utilizar de manera precoz los fármacos adecuados, porque estas infecciones aumentan si no acertamos con el tratamiento en las primeras horas.
|